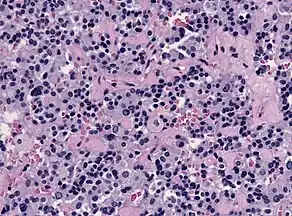

Thyrotropic cell
| Thyrotropic cell | |
|---|---|
| Details | |
| Location | Anterior pituitary |
| Function | Thyroid stimulating hormone secretion |
| Identifiers | |
| MeSH | D052684 |
| TH | H3.08.02.2.00005 |
| Anatomical terms of microanatomy | |
Overview
Thyrotropic cells (also called thyrotropes, or thyrotrophs) are endocrine cells in the anterior pituitary which produce thyroid-stimulating hormone (TSH) in response to thyrotropin-releasing hormone (TRH) from the hypothalamus.[1] Thyroid-stimulating hormone, or thyrotropin, triggers the release of thyroxine (T4) and triiodothyronine (T3) from the thyroid gland.[1] Thyrotropes comprise around 5% of the anterior pituitary lobe cells.[2]

Visualization
Thyrotropes appear basophilic in histological preparations. In the image displayed on the right, thyrotropes are the cells with the bluish-purple cytoplasm and the dark purple nucleus. Normal morphology of these cells is characterized by a round shape. However, these cells are best displayed under light microscopy performed following immunohistochemistry with TSH. This specific type of imaging allows for the visualization of the location of thyrotrophs in the anterior pituitary gland. Thyrotropic cells are clustered together in the anteromedial region of the gland.[3]
Development
Thyrotrophs can be identified via immunocytochemistry as early as the 12th week of fetal development, roughly at the same time that gonadotrophs can be detected. The active hormone, TSH, is detected at the 14th week of gestation. Transcription factors, such as Pit-1, GATA-2, and PROP1, influence cell proliferation and maturation.[3]
Mechanisms of Stimulation and Secretion
Effect of TRH Signaling
The hypothalamus secretes thyrotropin-releasing hormone (TRH) into portal veins, which carry this hormone to the anterior pituitary. Thyrotropin-releasing hormone is a relatively small peptide, containing only three amino acids. TRH stimulates the thyrotropic cells through the use of a phospholipase C second messenger system.[1] TRH binds to a class A G protein-coupled receptor on the surface of a thyrotropic cell, which is known as the thyrotropin-releasing hormone receptor (TRHR). Strong hydrogen bonding interactions stabilize the binding of TRH to TRHR. This binding event induces the coupling of Gαq/G11, which activates phospholipase C. Phospholipase C cleaves PIP2 into IP3. Inositol-1,4,5-triphosphate (IP3) binds to calcium channels along the membrane of the endoplasmic reticulum causing a conformational change, which opens the channels and subsequently releases Ca2+ ions into the cytosol of the thyrotrophs.[4]
Biosynthesis of Thyroid-Stimulating Hormone (TSH)
TSH consists of noncovalently associated subunits: an α-subunit that is conserved in other pituitary hormones and a β-subunit that gives the hormone its specificity. These subunits are synthesized from different genes. These subunits are transcribed in response to the signaling of TRH.[5] The direct pathway from the release of calcium ions to the expression of these genes in thyrotropic cells is unknown. The subunits are glycosylated and remodeled as they move through the cell. Further glycosylation of the subunits occurs as they progress through the secretory pathway.[6] Thyroid stimulating hormone is stored in the secretory granules of thyrotropic cells. Release of these granules is also induced by the signaling of TRH.[5]
Effect of Stimuli on the Release of TSH
Multiple neurogenic stimuli are known to affect the release of TSH from thyrotropes. Exposure to cold temperatures increases the secretion of TSH. This increased secretion results from the increased secretion of TRH, as the hypothalamus is excited by the change in body temperature.[1] Furthermore, emotions that activate the sympathetic nervous system—such as excitement and anxiety—decrease the secretion of TSH. The decrease in secretion is also connected to the change in body temperature. Activation of the sympathetic nervous system increases the body temperature, which then causes a decrease in TRH secretion and the subsequent decrease in TSH secretion.[1]
Thyroid hormones can have a direct inhibitory effect on thyrotropic cells, though the exact mechanism is unknown. At elevated levels of thyroxine, the rate of secretion of TSH decreases to near zero, as the body tries to maintain a relatively constant level of thyroid hormone in circulation.[1] However, the inhibitory effect of thyroid hormones may decrease in thyrotropic tumor cells. The receptor affinity for T3 significantly decreases for thyrotropic tumor cells in culture when compared to healthy thyrotropes, which reduces the regulatory effect.[7]
In addition, during pregnancy, the size of the pituitary gland increases, and consequently, the expression of TSH also increases. This increase in secretion of TSH likely results from the additional metabolic load that pregnant mothers experience in combination with the secretion of placental hormones.[1]
GLP-1 can also impact the secretion of TSH, though the exact mechanism is unknown. The presence of high affinity binding sites for GLP-1 was recently discovered in the thyrotropic cells of rodents. Understanding this pathway can help the formulation of treatments for type II diabetes mellitus, as there exists a strong association between metabolic diseases and thyroid dysfunction.[8]
Pathologies associated with Thyrotropic Cells
Thyrotroph Adenomas
This image shows the histology of a thyrotroph tumor. These thyrotroph tumors are referred to as thyrotroph adenomas, and are very rare. They typically present as functional macroadenomas and generally appear in individuals in their 50s. Thyrotroph adenomas are not well understood as they only comprise roughly 1% of all pituitary tumors.[9] These tumors typically result in increased secretion of TSH. Individuals with thyrotroph adenomas typically have hyperthyroidism and diffuse goitre. Diffuse goitre refers to the elongated enlargement of the thyroid gland that results from the increased expression of TSH.[10]
In histological staining, the thyrotropic cells appear more elongated and spindle shaped and are regularly accompanied by fibrosis.[9]
The World Health Organization (WHO) classifies pituitary tumors based on their transcription factors and hormones, as these factors provide insight into the cell lineage and purpose. Thyrotropic adenomas are identified as having the transcription factors, Pit-1, TEF, and GATA-2, and the hormones, β-TSH and α-subunit. Pit-1, in combination with thyrotroph embryonic factor (TEF), contributes to a cell's differentiation into a thyrotroph and helps stimulate the production of β-TSH. GATA-2 is a transcription factor for cells that belong to the Lhx gene family.[11] The heterodimer formation between the α-subunit and β-TSH is critical to TSH secretion. Disruption of the α-subunit gene results in a lack of TSH secretion, hypertrophy and hyperplasia of thyrotrophs, and decreased quantities of somatotrophs and lactotrophs.[12]
The molecular mechanism behind the formation of these tumors is not well understood, likely due to their low prevalence. Currently, no mutations have been identified in association with thyrotroph adenomas.[9]
In the presence of other pituitary tumors, the thyrotropic cells are unaffected.
Other Conditions
In individuals with primary hyperthyroidism, treatment via thyroid hormone therapy can reverse the hypertrophy and hyperplasia of the thyrotrophs.
Individuals with a rare form of dwarfism characterized by hypothyroidism lack thyrotropic cells altogether, as this syndrome results from a mutation in the Pit-1 gene.[3]
Excess iodine present in individuals with Graves’ Disease can induce thyrotoxicosis, which is the overexpression of thyroid hormone. Sudden overexpression of the thyroid hormone is referred to as thyroid storm. Thyroid storm results in substantial decreases in the amount of thyrotropic cells in the pituitary gland.[13] This decrease, if significant enough, can be fatal. However, with treatment, this decrease in the number of thyrotrophs can be reversed.[14]
See also
References
- 1 2 3 4 5 6 7 Guyton, A.C. & Hall, J.E. (2006) Textbook of Medical Physiology (11th ed.) Philadelphia: Elsevier Saunder ISBN 0-7216-0240-1
- ↑ "Costanzo, Linda S. (2014). "Physiology" (5th ed.). Philadelphia: Saunders Elsevier. ISBN 978-1-4557-0847-5
- 1 2 3 Werner, Sidney C.; Ingbar, Sidney H.; Braverman, Lewis E.; Utiger, Robert D., eds. (2005). Werner & Ingbar's the thyroid: a fundamental and clinical text, Volume 549 (9th ed.). Philadelphia: Lippincott Williams & Wilkins. pp. 26–35. ISBN 978-0-7817-5047-9.
- ↑ Yang, Fan; Zhang, Huanhuan; Meng, Xianyu; Li, Yingge; Zhou, Yingxin; Ling, Shenglong; Sun, Demeng; Lv, Pei; Liu, Lei; Shi, Pan; Tian, Changlin (2022). "Structural insights into thyrotropin-releasing hormone receptor activation by an endogenous peptide agonist or its orally administered analogue". Cell Research. 32 (9): 858–861. doi:10.1038/s41422-022-00646-6. ISSN 1748-7838. PMC 9437008. PMID 35352031.
- 1 2 Sarapura, Virginia D.; Samuel, Mary H. (2017-01-01), Melmed, Shlomo (ed.), "Chapter 6 - Thyroid-Stimulating Hormone", The Pituitary (Fourth Edition), Academic Press, pp. 163–201, doi:10.1016/b978-0-12-804169-7.00006-4, ISBN 978-0-12-804169-7, retrieved 2024-12-03
- ↑ Chin, William W.; Maloof, Farahe; Habener, Joel F. (1981). "Thyroid-stimulating hormone biosynthesis. Cellular processing, assembly, and release of subunits". Journal of Biological Chemistry. 256 (6): 3059–3066. doi:10.1016/s0021-9258(19)69724-3. PMID 7204390 – via Elsevier Science Direct.
- ↑ Gershengorn, M C; Geras, E; Marcus-Samuels, B E; Rebecchi, M J (1979). "Receptor affinity and biological potency of thyroid hormones in thyrotropic cells". American Journal of Physiology. Endocrinology and Metabolism. 237 (2): E142-6. doi:10.1152/ajpendo.1979.237.2.E142. ISSN 0193-1849. PMID 223453.
- ↑ Capuccio, Stefania; Scilletta, Sabrina; La Rocca, Francesca; Miano, Nicoletta; Di Marco, Maurizio; Bosco, Giosiana; Di Giacomo Barbagallo, Francesco; Scicali, Roberto; Piro, Salvatore; Di Pino, Antonino (2024). "Implications of GLP-1 Receptor Agonist on Thyroid Function: A Literature Review of Its Effects on Thyroid Volume, Risk of Cancer, Functionality and TSH Levels". Biomolecules. 14 (6): 687. doi:10.3390/biom14060687. ISSN 2218-273X. PMC 11202033. PMID 38927090.
- 1 2 3 Larkin, Sarah; Ansorge, Olaf (2000), Feingold, Kenneth R.; Anawalt, Bradley; Blackman, Marc R.; Boyce, Alison (eds.), "Pathology And Pathogenesis Of Pituitary Adenomas And Other Sellar Lesions", Endotext, South Dartmouth (MA): MDText.com, Inc., PMID 28402620, retrieved 2024-12-03
- ↑ Can, Ahmet S.; Rehman, Anis (2024), "Goiter", StatPearls, Treasure Island (FL): StatPearls Publishing, PMID 32965832, retrieved 2024-12-03
- ↑ Al-Shraim, Mubarak; Asa, Sylvia L. (2006-01-01). "The 2004 World Health Organization classification of pituitary tumors: What is new?". Acta Neuropathologica. 111 (1): 1–7. doi:10.1007/s00401-005-1093-6. ISSN 1432-0533. PMID 16328527.
- ↑ Stahl, Justin H.; Kendall, Susan K.; Brinkmeier, Michelle L.; Greco, Tamara L.; Watkins-Chow, Dawn E.; Campos-Barros, Angel; Lloyd, Ricardo V.; Camper, Sally A. (1999-04-01). "Thyroid Hormone Is Essential for Pituitary Somatotropes and Lactotropes*". Endocrinology. 140 (4): 1884–1892. doi:10.1210/endo.140.4.6627. ISSN 0013-7227. PMID 10098528.
- ↑ Blick, Carly; Nguyen, Minhthao; Jialal, Ishwarlal (2024), "Thyrotoxicosis", StatPearls, Treasure Island (FL): StatPearls Publishing, PMID 29489233, retrieved 2024-12-03
- ↑ Toro-Tobon, David; Stan, Marius N. (2024-09-24), "Graves' Disease and the Manifestations of Thyrotoxicosis", Endotext [Internet], MDText.com, Inc., PMID 25905422, retrieved 2024-12-03